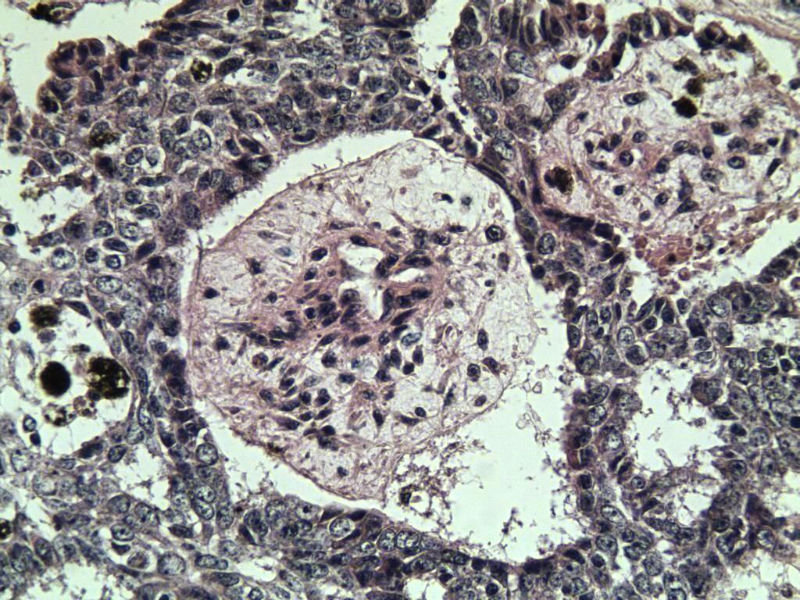
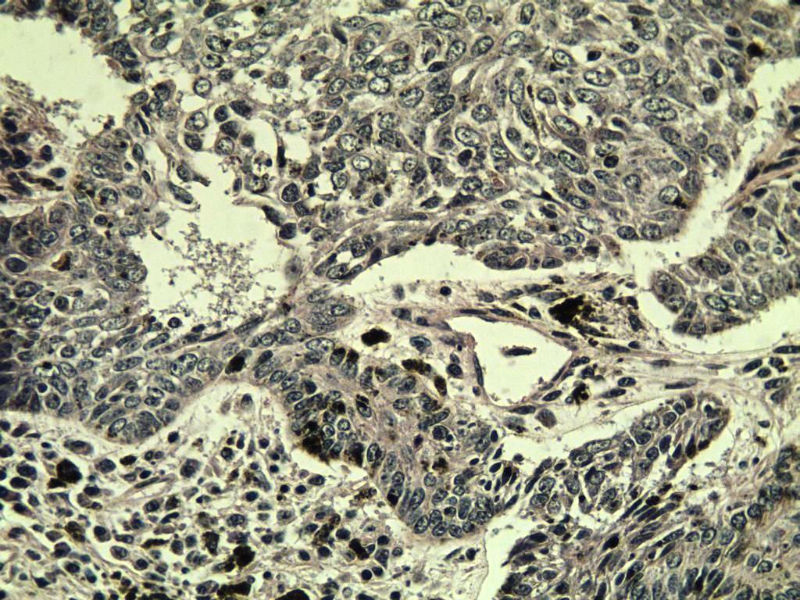

| 图片: | |
|---|---|
| 名称: | |
| 描述: | |
- 面部包块
女 67岁 临床考虑面部色素痣 1*0.8 cm 请问各位老师 这是什么? 谢谢!
名称:图1
描述:a292.Jpg

名称:图1
描述:a292.Jpg

名称:图2
描述:a293.Jpg

名称:图3
描述:a294.Jpg

名称:图4
描述:a295.Jpg

名称:图5
描述:a296.Jpg

名称:图6
描述:a297.Jpg

名称:图7
描述:a298.Jpg

名称:图8
描述:a299.Jpg

名称:图9
描述:a300.Jpg

名称:图10
描述:a301.Jpg

名称:图11
描述:a302.Jpg

名称:图12
描述:a303.Jpg

名称:图13
描述:a304.Jpg

名称:图14
描述:a305.Jpg

名称:图15
描述:a306.Jpg

名称:图16
描述:a307.Jpg

名称:图17
描述:a308.Jpg

名称:图18
描述:a309.Jpg

名称:图19
描述:a310.Jpg
标签:
×参考诊断
这是另外一个 75岁 男性 脸上有一直径0.8cm新生物 是鳞癌吗? 感觉细胞异型性不够大.
名称:图1
描述:a271.Jpg

名称:图1
描述:a271.Jpg

名称:图2
描述:a272.Jpg

名称:图3
描述:a273.Jpg

名称:图4
描述:a274.Jpg

名称:图5
描述:a275.Jpg

名称:图6
描述:a276.Jpg

名称:图7
描述:a277.Jpg

名称:图8
描述:a278.Jpg

名称:图9
描述:a279.Jpg

名称:图10
描述:a280.Jpg

名称:图11
描述:a281.Jpg

名称:图12
描述:a282.Jpg

名称:图13
描述:a283.Jpg

名称:图14
描述:a284.Jpg
名称:图15
描述:a285.Jpg

名称:图16
描述:a286.Jpg

名称:图17
描述:a287.Jpg

名称:图18
描述:a288.Jpg

名称:图19
描述:a289.Jpg

名称:图20
描述:a290.Jpg
名称:图21
描述:a291.Jpg























